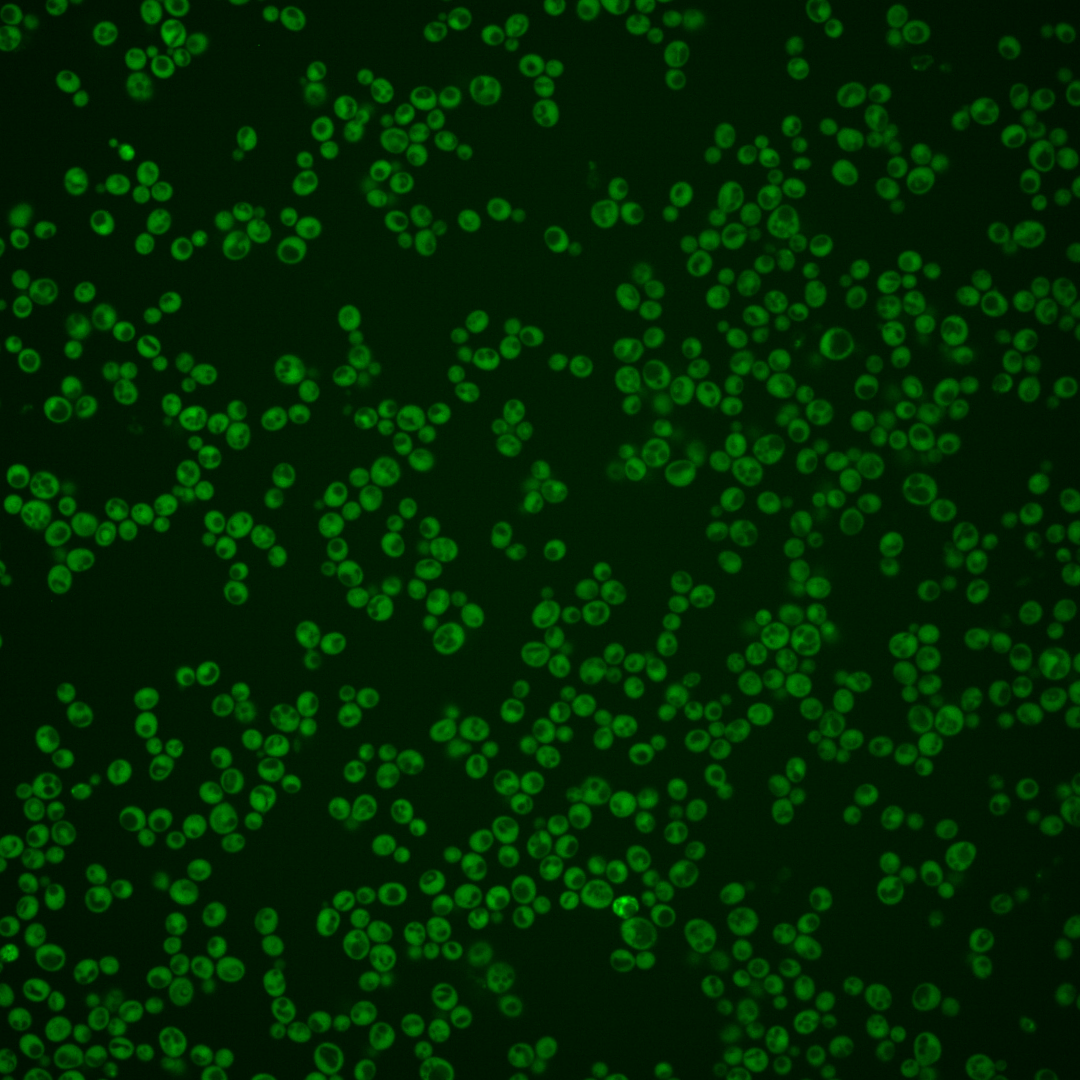
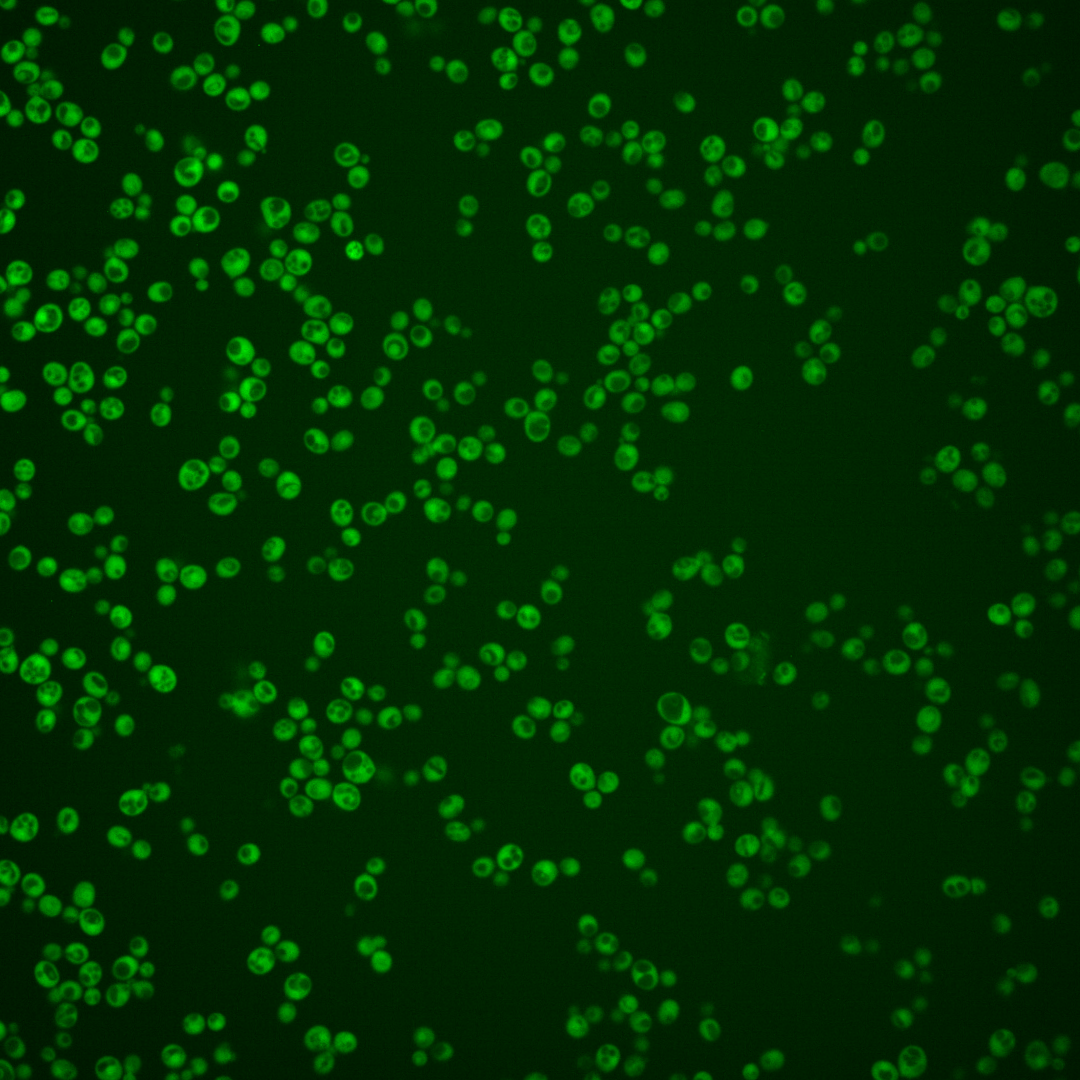
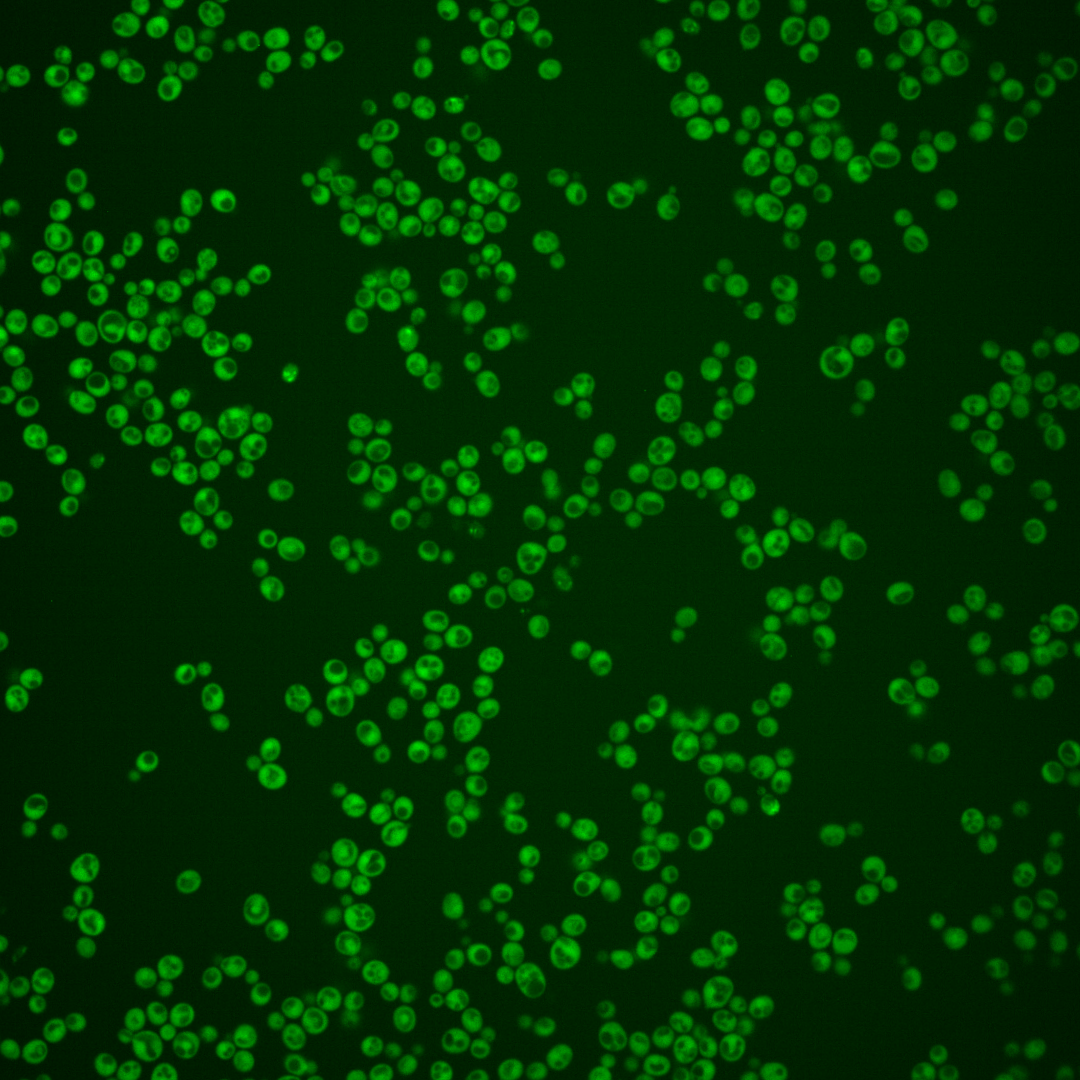
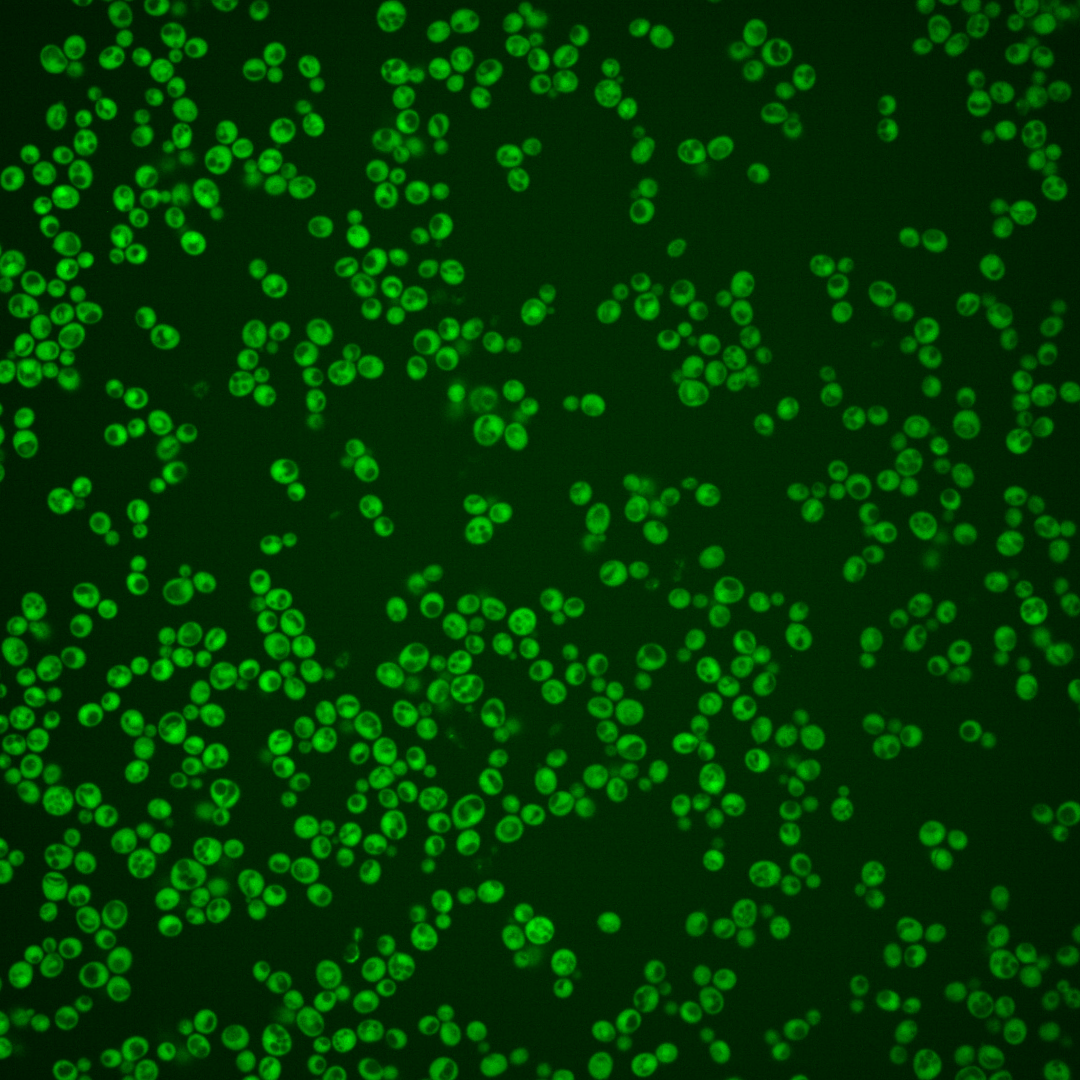
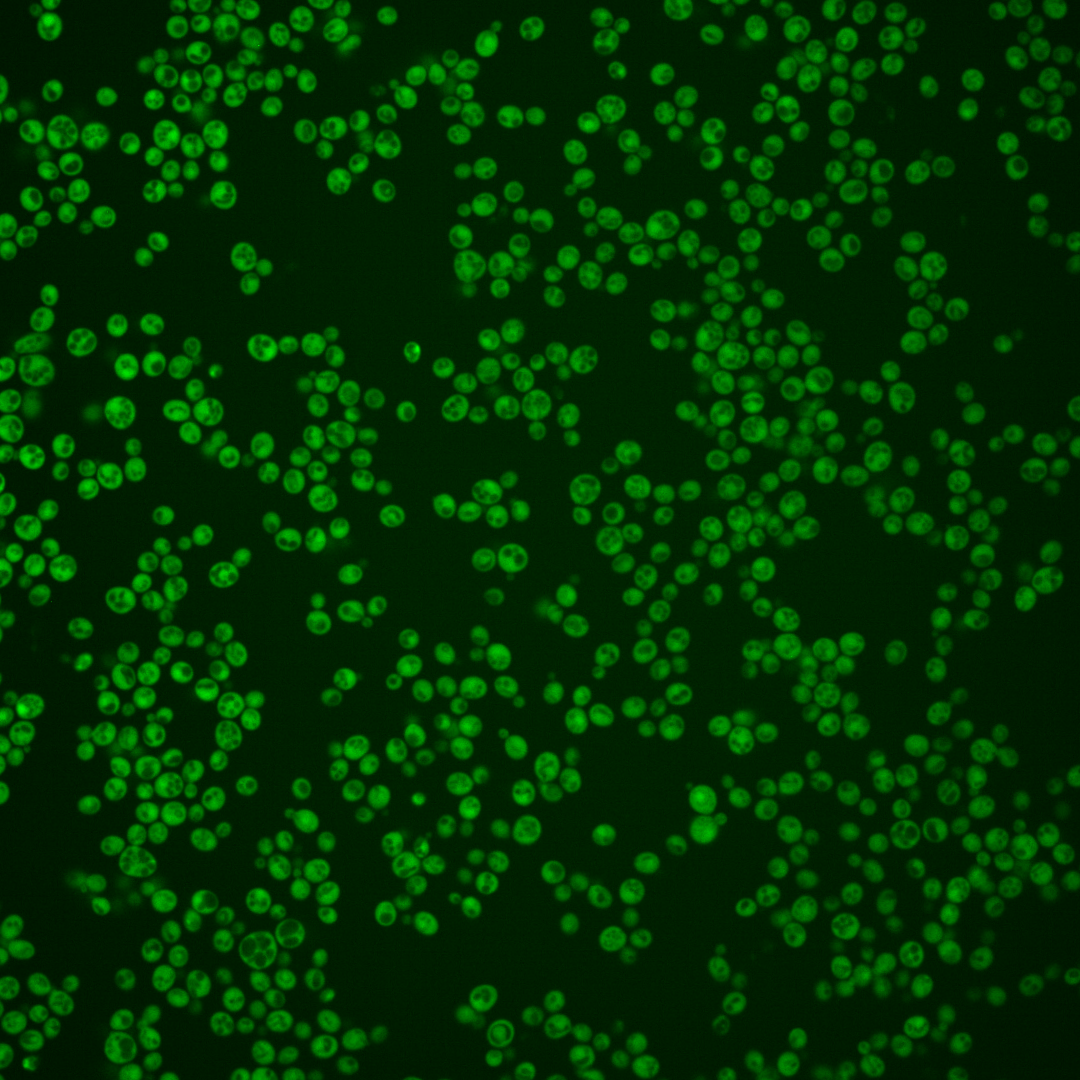
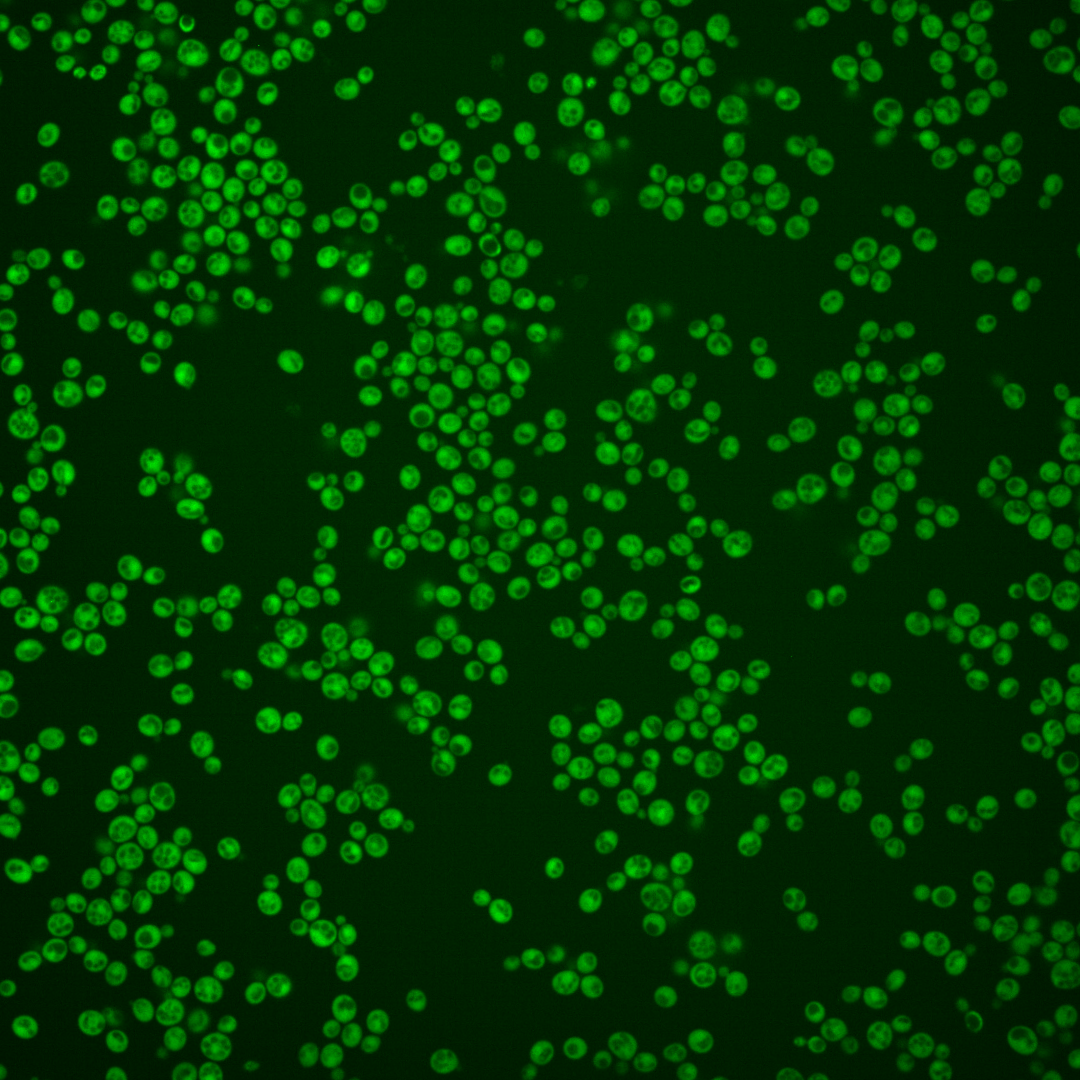
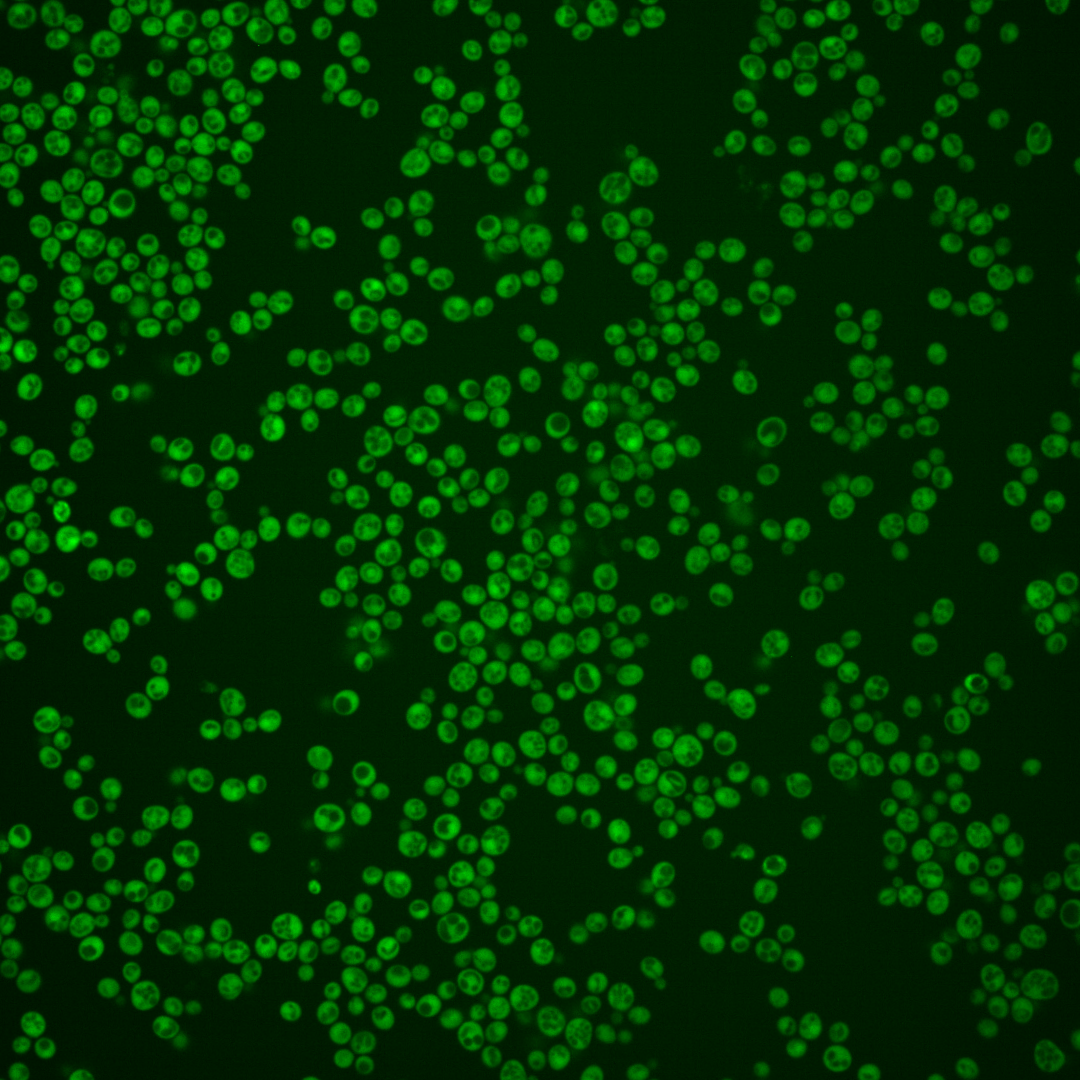

| Standard name | |
|---|---|
| Human Ortholog | |
| Description | Methyltransferase involved in methylation of histone H4 Lys5, -8, -12; S-adenosylmethionine-dependent; zinc-finger protein, contains one canonical and two unusual fingers in unusual arrangements; deletion enhances replication of positive-strand RNA virus |
Micrographs




















































































Sub-cellular Localization
Yeast GFP Assignment
Protein Abundance
Localization Change
External localization resources
| ensLOC | DeepLoc | |||||||||||||||||||||||
|---|---|---|---|---|---|---|---|---|---|---|---|---|---|---|---|---|---|---|---|---|---|---|---|---|
| Localization | WT1 | WT2 | WT3 | RAP60 | RAP140 | RAP220 | RAP300 | RAP380 | RAP460 | RAP540 | RAP620 | RAP700 | HU80 | HU120 | HU160 | rpd3Δ_1 | rpd3Δ_2 | rpd3Δ_3 | WT1 | WT2 | WT3 | AF100 | AF140 | AF180 |
| Cortical Patches | 0 | 0 | 0 | 0 | 0 | 0 | 0 | 0 | 0 | 0 | 0 | 0 | 0 | 0 | 0 | 0 | 0 | 0 | 0 | 0 | 1 | 0 | 0 | 2 |
| Bud | 0 | 0 | 2 | 3 | 1 | 0 | 0 | 2 | 9 | 3 | 0 | 0 | 0 | 0 | 0 | 1 | 0 | 0 | 0 | 0 | 0 | 0 | 0 | 1 |
| Bud Neck | 0 | 0 | 0 | 0 | 0 | 0 | 0 | 0 | 0 | 0 | 0 | 0 | 0 | 0 | 0 | 0 | 0 | 0 | 0 | 0 | 0 | 0 | 0 | 0 |
| Bud Site | 0 | 0 | 0 | 0 | 0 | 0 | 0 | 0 | 0 | 0 | 0 | 0 | 0 | 0 | 0 | 0 | 0 | 0 | – | – | – | – | – | – |
| Cell Periphery | 4 | 2 | 1 | 0 | 2 | 7 | 7 | 1 | 6 | 5 | 2 | 3 | 2 | 0 | 1 | 4 | 5 | 7 | 0 | 0 | 0 | 0 | 0 | 0 |
| Cytoplasm | 164 | 228 | 148 | 143 | 215 | 321 | 304 | 325 | 231 | 236 | 117 | 104 | 268 | 433 | 417 | 333 | 147 | 125 | 155 | 224 | 137 | 145 | 324 | 279 |
| Endoplasmic Reticulum | 0 | 3 | 0 | 3 | 1 | 0 | 2 | 0 | 4 | 4 | 2 | 7 | 3 | 1 | 1 | 18 | 5 | 3 | 0 | 0 | 0 | 1 | 3 | 4 |
| Endosome | 0 | 0 | 0 | 0 | 0 | 0 | 0 | 1 | 0 | 0 | 0 | 0 | 0 | 0 | 0 | 1 | 0 | 0 | 1 | 0 | 1 | 0 | 1 | 2 |
| Golgi | 0 | 0 | 0 | 0 | 0 | 0 | 0 | 0 | 0 | 0 | 0 | 0 | 0 | 0 | 0 | 0 | 0 | 0 | 1 | 0 | 0 | 0 | 0 | 1 |
| Mitochondria | 0 | 2 | 7 | 4 | 11 | 45 | 90 | 91 | 94 | 110 | 56 | 54 | 1 | 2 | 0 | 4 | 0 | 1 | 1 | 0 | 3 | 1 | 0 | 3 |
| Nucleus | 8 | 0 | 5 | 0 | 0 | 0 | 4 | 7 | 4 | 4 | 3 | 4 | 2 | 1 | 0 | 1 | 1 | 1 | 0 | 1 | 1 | 0 | 1 | 0 |
| Nuclear Periphery | 0 | 0 | 0 | 0 | 0 | 0 | 3 | 1 | 0 | 5 | 1 | 0 | 0 | 0 | 0 | 0 | 0 | 0 | 0 | 0 | 0 | 0 | 1 | 1 |
| Nucleolus | 1 | 0 | 0 | 0 | 0 | 0 | 0 | 1 | 0 | 0 | 0 | 1 | 0 | 0 | 0 | 0 | 1 | 0 | 0 | 0 | 0 | 0 | 0 | 0 |
| Peroxisomes | 0 | 0 | 0 | 0 | 0 | 0 | 0 | 0 | 0 | 0 | 0 | 0 | 0 | 0 | 0 | 0 | 0 | 0 | 0 | 0 | 0 | 0 | 0 | 1 |
| SpindlePole | 0 | 0 | 0 | 0 | 0 | 0 | 0 | 0 | 0 | 0 | 0 | 0 | 0 | 0 | 0 | 0 | 0 | 0 | 0 | 0 | 1 | 0 | 0 | 0 |
| Vac/Vac Membrane | 0 | 0 | 0 | 2 | 6 | 4 | 6 | 35 | 10 | 19 | 2 | 7 | 0 | 2 | 2 | 5 | 12 | 2 | 4 | 1 | 10 | 2 | 3 | 4 |
| Unique Cell Count | 168 | 232 | 155 | 148 | 225 | 343 | 370 | 406 | 299 | 320 | 155 | 151 | 272 | 438 | 420 | 339 | 156 | 128 | 167 | 229 | 160 | 155 | 341 | 308 |
| Labelled Cell Count | 177 | 235 | 163 | 155 | 236 | 377 | 416 | 464 | 358 | 386 | 183 | 180 | 276 | 439 | 421 | 367 | 171 | 139 | 167 | 229 | 160 | 155 | 341 | 308 |
Yeast GFP Assignment
Protein Abundance
| Screen | WT1 | WT2 | WT3 | RAP60 | RAP140 | RAP220 | RAP300 | RAP380 | RAP460 | RAP540 | RAP620 | RAP700 | HU80 | HU120 | HU160 | rpd3Δ_1 | rpd3Δ_2 | rpd3Δ_3 | AF100 | AF140 | AF180 |
|---|---|---|---|---|---|---|---|---|---|---|---|---|---|---|---|---|---|---|---|---|---|
| Mean Cell GFP Intensity (1e-4) | 7.9 | 8.5 | 6.0 | 6.2 | 6.3 | 5.7 | 4.9 | 5.5 | 5.2 | 4.8 | 4.8 | 4.7 | 8.9 | 8.5 | 8.1 | 9.6 | 11.4 | 12.4 | 8.7 | 8.9 | 9.7 |
| Std Deviation (1e-4) | 1.3 | 1.3 | 1.1 | 0.8 | 1.2 | 1.0 | 1.2 | 1.1 | 1.1 | 1.0 | 1.0 | 0.8 | 1.4 | 1.3 | 1.4 | 2.0 | 3.0 | 2.7 | 1.4 | 1.5 | 1.5 |
| Intensity Change (Log2) | – | – | – | 0.05 | 0.07 | -0.07 | -0.29 | -0.12 | -0.2 | -0.31 | -0.32 | -0.37 | 0.57 | 0.51 | 0.44 | 0.68 | 0.93 | 1.04 | 0.53 | 0.57 | 0.7 |
Localization Change
| Localization | RAP60 | RAP140 | RAP220 | RAP300 | RAP380 | RAP460 | RAP540 | RAP620 | RAP700 | HU80 | HU120 | HU160 | rpd3Δ_1 | rpd3Δ_2 | rpd3Δ_3 |
|---|---|---|---|---|---|---|---|---|---|---|---|---|---|---|---|
| Cortical Patches | 0 | 0 | 0 | 0 | 0 | 0 | 0 | 0 | 0 | 0 | 0 | 0 | 0 | 0 | 0 |
| Bud | 0 | 0 | 0 | 0 | 0 | 0 | 0 | 0 | 0 | 0 | 0 | 0 | 0 | 0 | 0 |
| Bud Neck | 0 | 0 | 0 | 0 | 0 | 0 | 0 | 0 | 0 | 0 | 0 | 0 | 0 | 0 | 0 |
| Bud Site | 0 | 0 | 0 | 0 | 0 | 0 | 0 | 0 | 0 | 0 | 0 | 0 | 0 | 0 | 0 |
| Cell Periphery | 0 | 0 | 0 | 0 | 0 | 0 | 0 | 0 | 0 | 0 | 0 | 0 | 0 | 0 | 0 |
| Cytoplasm | 0.5 | 0 | -0.8 | -4.0 | -4.5 | -5.0 | -5.6 | -5.0 | -6.1 | 1.9 | 2.6 | 3.1 | 1.8 | -0.5 | 1.0 |
| Endoplasmic Reticulum | 0 | 0 | 0 | 0 | 0 | 0 | 0 | 0 | 0 | 0 | 0 | 0 | 2.9 | 0 | 0 |
| Endosome | 0 | 0 | 0 | 0 | 0 | 0 | 0 | 0 | 0 | 0 | 0 | 0 | 0 | 0 | 0 |
| Golgi | 0 | 0 | 0 | 0 | 0 | 0 | 0 | 0 | 0 | 0 | 0 | 0 | 0 | 0 | 0 |
| Mitochondria | -0.8 | 0.2 | 2.9 | 5.3 | 5.0 | 6.5 | 0 | 0 | 0 | 0 | 0 | 0 | 0 | 0 | 0 |
| Nucleus | 0 | 0 | 0 | 0 | 0 | 0 | 0 | 0 | 0 | 0 | 0 | 0 | 0 | 0 | 0 |
| Nuclear Periphery | 0 | 0 | 0 | 0 | 0 | 0 | 0 | 0 | 0 | 0 | 0 | 0 | 0 | 0 | 0 |
| Nucleolus | 0 | 0 | 0 | 0 | 0 | 0 | 0 | 0 | 0 | 0 | 0 | 0 | 0 | 0 | 0 |
| Peroxisomes | 0 | 0 | 0 | 0 | 0 | 0 | 0 | 0 | 0 | 0 | 0 | 0 | 0 | 0 | 0 |
| SpindlePole | 0 | 0 | 0 | 0 | 0 | 0 | 0 | 0 | 0 | 0 | 0 | 0 | 0 | 0 | 0 |
| Vacuole | 0 | 0 | 0 | 0 | 3.8 | 0 | 3.1 | 0 | 0 | 0 | 0 | 0 | 0 | 3.5 | 0 |
External localization resources
Images






























Protein Concentration and Protein Localization Data
| R1 | R2 | R3 | ||||||||||||||||
|---|---|---|---|---|---|---|---|---|---|---|---|---|---|---|---|---|---|---|
| G1 Pre-START | G1 Post-START | S/G2 | Metaphase | Anaphase | Telophase | G1 Pre-START | G1 Post-START | S/G2 | Metaphase | Anaphase | Telophase | G1 Pre-START | G1 Post-START | S/G2 | Metaphase | Anaphase | Telophase | |
| Concentration | 4.1311 | 5.7848 | 4.8644 | 4.6549 | 4.1956 | 5.0693 | 3.2908 | 3.9865 | 3.598 | 3.157 | 2.7616 | 3.5308 | 2.8961 | 4.7167 | 4.5491 | 3.8698 | 4.5323 | 4.552 |
| Actin | 0.0149 | 0.001 | 0.0255 | 0.0154 | 0.0318 | 0.0009 | 0.0535 | 0.0005 | 0.0074 | 0.0005 | 0.0506 | 0.0017 | 0.0318 | 0.0004 | 0.0006 | 0.0004 | 0.0007 | 0.0003 |
| Bud | 0.0009 | 0.0002 | 0.0082 | 0.0012 | 0.0007 | 0.0001 | 0.0001 | 0.0001 | 0.0005 | 0.0001 | 0.0003 | 0.0005 | 0.0001 | 0 | 0.0001 | 0.0001 | 0.0001 | 0 |
| Bud Neck | 0.0007 | 0.0001 | 0.0082 | 0.0009 | 0.0024 | 0.0008 | 0.0001 | 0.0001 | 0.0002 | 0.0002 | 0.0008 | 0.0005 | 0.0002 | 0.0001 | 0.0001 | 0.0003 | 0.0004 | 0.0005 |
| Bud Periphery | 0.0004 | 0.0001 | 0.0016 | 0.0013 | 0.0004 | 0 | 0.0001 | 0 | 0.0003 | 0 | 0.0002 | 0.0003 | 0.0002 | 0 | 0 | 0 | 0 | 0 |
| Bud Site | 0.0031 | 0.0006 | 0.0042 | 0.0038 | 0.0011 | 0.0001 | 0.0005 | 0.0005 | 0.0007 | 0.0001 | 0.0007 | 0 | 0.0006 | 0.0002 | 0.0001 | 0.0001 | 0.0001 | 0 |
| Cell Periphery | 0.0003 | 0.0002 | 0.0005 | 0.0001 | 0.0002 | 0.0001 | 0.0001 | 0.0001 | 0.0001 | 0 | 0.0001 | 0 | 0.0003 | 0 | 0.0001 | 0 | 0 | 0 |
| Cytoplasm | 0.8005 | 0.9381 | 0.8721 | 0.9059 | 0.8558 | 0.9507 | 0.778 | 0.9383 | 0.8235 | 0.9867 | 0.8222 | 0.95 | 0.7294 | 0.9829 | 0.8903 | 0.9381 | 0.9723 | 0.9592 |
| Cytoplasmic Foci | 0.0287 | 0.0052 | 0.0091 | 0.0186 | 0.007 | 0.0054 | 0.0024 | 0.0014 | 0.0253 | 0.0019 | 0.0316 | 0.0034 | 0.0165 | 0.0012 | 0.0019 | 0.0022 | 0.0034 | 0.0022 |
| Eisosomes | 0.0004 | 0 | 0.0005 | 0.0001 | 0.0002 | 0 | 0.0001 | 0 | 0.0001 | 0 | 0.0001 | 0 | 0.0021 | 0 | 0 | 0 | 0 | 0 |
| Endoplasmic Reticulum | 0.0053 | 0.0024 | 0.0034 | 0.0016 | 0.0023 | 0.0029 | 0.003 | 0.0026 | 0.0051 | 0.0021 | 0.002 | 0.0018 | 0.0065 | 0.0082 | 0.0031 | 0.0417 | 0.0114 | 0.0023 |
| Endosome | 0.0123 | 0.004 | 0.006 | 0.0113 | 0.0041 | 0.0023 | 0.0005 | 0.0004 | 0.0157 | 0.001 | 0.0081 | 0.001 | 0.0166 | 0.0007 | 0.001 | 0.0031 | 0.002 | 0.0014 |
| Golgi | 0.0038 | 0.0005 | 0.0026 | 0.004 | 0.002 | 0.0003 | 0.0012 | 0.0001 | 0.0126 | 0.0001 | 0.0188 | 0.0001 | 0.0232 | 0.0001 | 0.0001 | 0.0001 | 0.0002 | 0 |
| Lipid Particles | 0.003 | 0.0004 | 0.0019 | 0.0034 | 0.0012 | 0.0001 | 0.0005 | 0 | 0.0037 | 0 | 0.0131 | 0 | 0.1035 | 0 | 0 | 0 | 0.0001 | 0 |
| Mitochondria | 0.0044 | 0.0001 | 0.0039 | 0.002 | 0.0024 | 0.0002 | 0.0003 | 0 | 0.0023 | 0.0001 | 0.0011 | 0.0001 | 0.0102 | 0 | 0 | 0.0001 | 0.0001 | 0 |
| None | 0.0951 | 0.044 | 0.0397 | 0.0071 | 0.0773 | 0.0323 | 0.1555 | 0.0545 | 0.0928 | 0.0048 | 0.0047 | 0.038 | 0.0246 | 0.0033 | 0.1005 | 0.0091 | 0.0071 | 0.0327 |
| Nuclear Periphery | 0.0066 | 0.0006 | 0.0009 | 0.0005 | 0.0008 | 0.0005 | 0.0004 | 0.0004 | 0.001 | 0.0006 | 0.0003 | 0.0005 | 0.0025 | 0.0012 | 0.0006 | 0.0021 | 0.0007 | 0.0002 |
| Nucleolus | 0.0004 | 0 | 0.0006 | 0.0001 | 0 | 0 | 0 | 0 | 0.0002 | 0 | 0 | 0 | 0.0002 | 0 | 0 | 0 | 0 | 0 |
| Nucleus | 0.004 | 0.001 | 0.0019 | 0.0016 | 0.0021 | 0.0019 | 0.0011 | 0.0005 | 0.0009 | 0.0012 | 0.0004 | 0.001 | 0.0012 | 0.0011 | 0.0008 | 0.0015 | 0.0009 | 0.0007 |
| Peroxisomes | 0.0084 | 0.0002 | 0.0062 | 0.0188 | 0.0066 | 0.0002 | 0.0022 | 0 | 0.0057 | 0 | 0.0435 | 0.0001 | 0.0275 | 0 | 0 | 0 | 0 | 0 |
| Punctate Nuclear | 0.0056 | 0.0003 | 0.0019 | 0.0006 | 0.0005 | 0.0004 | 0.0002 | 0.0001 | 0.0012 | 0.0001 | 0.0012 | 0.0009 | 0.0014 | 0.0002 | 0.0002 | 0.0002 | 0.0003 | 0.0001 |
| Vacuole | 0.001 | 0.0006 | 0.0011 | 0.0015 | 0.0006 | 0.0007 | 0.0002 | 0.0002 | 0.0004 | 0.0004 | 0.0003 | 0.0002 | 0.0006 | 0.0002 | 0.0003 | 0.0007 | 0.0003 | 0.0001 |
| Vacuole Periphery | 0.0003 | 0.0001 | 0.0002 | 0.0003 | 0.0002 | 0.0001 | 0 | 0 | 0.0002 | 0.0001 | 0.0001 | 0 | 0.0008 | 0 | 0 | 0.0001 | 0 | 0 |
Sequencing Data
| R1 | R2 | |||||||||
|---|---|---|---|---|---|---|---|---|---|---|
| G1 Post-START | S/G2 | Metaphase | Anaphase | Telophase | G1 Post-START | S/G2 | Metaphase | Anaphase | Telophase | |
| Gene Expression | 17.4479 | 13.7257 | 14.3516 | 18.591 | 23.9793 | 20.2283 | 21.7632 | 20.6494 | 19.3352 | 18.8121 |
| Translational Efficiency | 1.9387 | 2.7069 | 1.7816 | 1.4429 | 1.2397 | 1.2351 | 1.4736 | 1.3363 | 1.3143 | 1.5773 |
Hit Data
| Dataset | Hit |
|---|---|
| Protein Concentration | ✘ |
| Protein Localization | ✘ |
| Gene Expression | ✘ |
| Translational Efficiency | ✘ |
Endocytosis
| Temp | Actin Patch (Sac6-tdTomato) | Cortical Patch (Sla1-GFP) | Late Endosome (Snf7-GFP) | Vacuole (Vph1-GFP) |
|---|---|---|---|---|
| 37℃ | ||||
| RT |
Cell Cycle Omics
CYCLoPs (Set5-GFP)
| Gene / Allele | Actin Patch (Sac6-tdTomato) | Cortical Patch (Sla1-GFP) | Late Endosome (Snf7-GFP) | Vacuole (Sac6-tdTomato) |
|---|
| Gene | Images |
|---|
| Gene | Images |
|---|
Images are not yet available
Images are not yet available